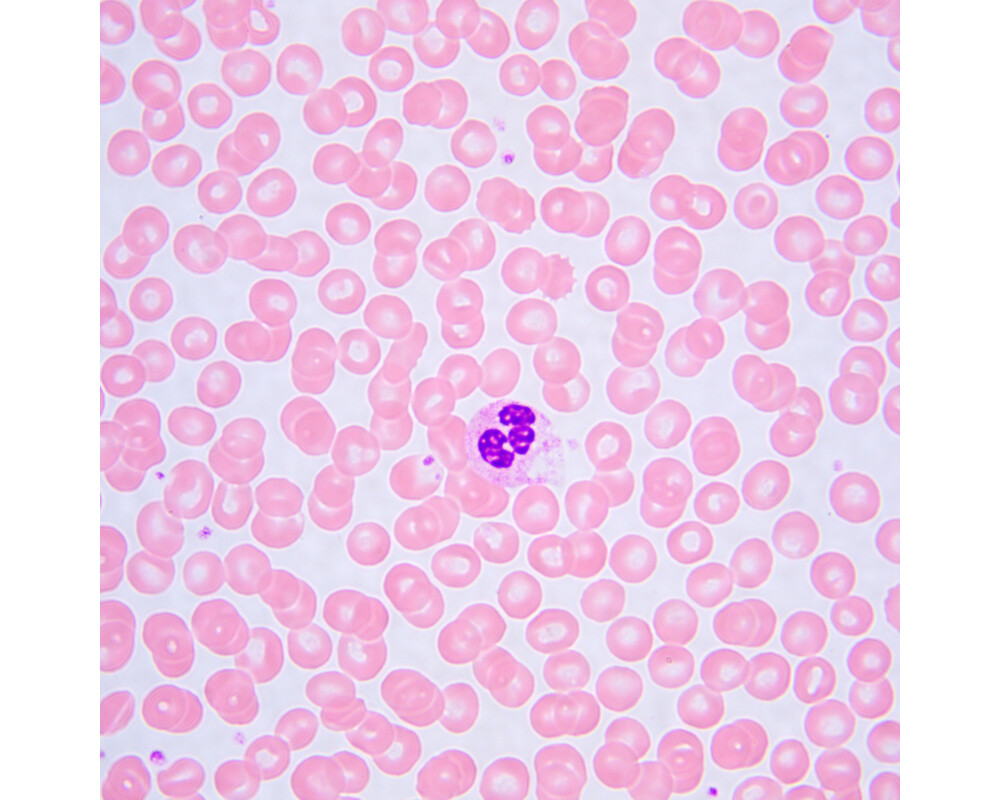

- Начало
- Оптични уреди и измервателни инструменти
- Микроскопи
- Magus
- Биологичен MAGUS Bio 240T (ID: 722942)
Микроскоп Биологичен MAGUS Bio 240T 83477
кодирана револверна глава, планахроматични обективи, светодиоден илюминатор 3 W и интелигентна система за управление на осветлението
Гаранция:
0.0
от 5.0
(0)
Купи и събери
10 точки
Плати по-лесно и сигурно с
ID: 722942
Характеристики
| Тип | биологичен, светлина/оптичен |
| Подходящо за | лабораторно/медицинско |
| Употреба | за професионалисти, опитни потребители |
| Монтаж и инсталиране | сложен |
| Technique | на светлото поле |
| Head | глава Gemel (Siedentopf, завъртане на 360°), разделяне на лъчите 0/100, 100/0 |
| Head angle | 30 ° |
| Revolver | 4 обектива, кодирани |
| Увеличение, x | 40 — 1000 x |
| Окуляри | 10x/20 mm, голямо разстояние от очите |
| Диаметър на окуляра | 23.2 мм. |
| Диоптрична корекция на окуляра | ±5 диоптъра на двете тръби |
| Фокусиране |
коаксиален
грубо (17 mm 37,7 mm/кръг със застопоряващ бутон и бутон за регулиране на затягането) и фино (0,002 mm 0,2 mm/кръг) |
| Diaphragm | регулируема апертура |
| Objectives | планахроматични с корекция до безкрайност: 4x/0,10; 10x/0,25; 40xs/0,65; 100xs/1,25 имерсионен; парфокално разстояние: 45 mm |
| Филтри | да |
| Разстояние между окулярите (IPD), mm | 47 — 75 мм. |
| Condenser | кондензер на Abbe N.A. 1,25 с регулируема диафрагма на апертурата и цветно кодирано увеличение на обективите |
| Light source type | светодиодно |
| Light source | светодиод 3 W, с регулиране на цветната температура (3000–7000 K) |
| Light source placement | долно |
| Brightness control |
|
| Stage | 180x130 мм. |
| Stage adjustment | 74/30 |
| Stage features | двуосова механична предметна маса, без рейка за позициониране |
| Размери на продукта | 45x30x65 cm см. |
| Захранване | 100–240 V, 50/60 Hz, захранващият адаптер за променлив/постоянен ток се намира в специално гнездо на гърба на стойката, променливотокова мрежа |
| Тегло | 9.8 kg кг. |
| Други характеристики | автоматично регулиране на яркостта при превключване на обективите, екран с течнокристален дисплей за състоянието, режим „еко“, „спящ“ режим |
| Гаранция | 24 месеца |
| Код на продукта | 83477 |
Виж повече
Допълнителна информация
<p>Микроскопът е подходящ за наблюдение на прозрачни и полупрозрачни биологични проби, като натривки и напречни сечения, по метода на светлото поле с преминаваща светлина.<br />
Кодираната револверна глава поддържа удобно за наблюдение ниво на яркостта при превключване на обективите. Интелигентното управление на осветлението на микроскопа увеличава комфорта и скоростта на рутинната работа на научния работник. “Интелигентните” функции помагат на студентите за по-лесно навлизане в професията и придобиване на необходимия професионален опит.<br />
Практическите аспекти играят важна роля за учебните микроскопи: размерът, теглото, лесното съхранение на кабелите и самите микроскопи са важни за ежедневната употреба. Поради малките си размери и тегло микроскопът е удобен за преместване по масата. Микроскопът не заема много място при съхранение.</p>
<p><strong>Глава на микроскопа</strong></p>
<p>Тринокулярна глава с коригирана до безкрайност оптика. Окулярните тръби могат да се въртят на 360°. Потребителят може да регулира разстоянието от очите на окулярите, за да отговаря на неговия ръст. В тринокулярната тръба вместо окуляр е монтирана цифрова камера. Разделяне на лъчите 0/100 и 100/0.<br />
Комплектът включва окуляри 10x/20 mm с голямо разстояние от очите. Плоски гумени накрайници за окулярите без изпъкнали части предпазват оптичните елементи на очилата от надраскване.<br />
Регулирането на диоптъра се извършва директно на микроскопа: на двете окулярни тръби има пръстени за регулиране на диоптъра.</p>
<p><strong>Револверна глава</strong></p>
<p>Кодираната револверна глава за 4 обектива е ориентирана навътре: потребителят може да вижда поставения в оптичния път обектив, а пространството над предметната маса е свободно.</p>
<p><strong>Поддържане на комфортни нива на яркост при превключване на увеличенията</strong></p>
<p>Обективите с различно увеличение предават светлина с различна интензивност и поради това при всяка смяна на обектива трябва да се регулира яркостта на светлината. Освен това яркостта се увеличава рязко при превключване от обектив с по-голямо увеличение към такъв с по-малко увеличение. Рязкото увеличаване на яркостта уморява очите. MAGUS Bio 240Т е оборудван с интелигентно управление на яркостта. Микроскопът запаметява яркостта за всеки избран от потребителя обектив и задава автоматично съответната яркост при завъртане на револверната глава. Интелигентното управление намалява необходимото време за регулиране на яркостта. MAGUS Bio 240Т увеличава комфорта на потребителя и пести време, дори когато работата изисква честа смяна на увеличението.</p>
<p><strong>Фокусиращ механизъм</strong></p>
<p>От двете страни в основата на микроскопа са монтирани коаксиални бутони за грубо и фино фокусиране. Потребителят може да постави ръцете си върху масата и да заеме отпусната поза, докато наблюдава. Регулирането на фокуса е плавно и без усилия.<br />
Бутонът за застопоряване при грубо фокусиране Ви предоставя възможност за бързо регулиране на микроскопа след смяна на обекта на изследването. Бутонът се намира от лявата страна на микроскопа на оста на механизма за фокусиране.<br />
Пръстенът от дясната страна регулира усилието при грубото фокусиране. Потребителят настройва удобното за работа усилие.</p>
<p><strong>Предметна маса</strong></p>
<p>За осигуряване на ергономична работа с работната маса тя няма рейка за позициониране по оста X. Задвижваният с ремък механизъм осигурява възможност за плавно преместване на образеца. Държачът за образеца е закрепен с два винта и може да се отстранява лесно по време на ръчно сканиране.</p>
<p><strong>Кондензер Abbe</strong></p>
<p>Имерсионен кондензер на Abbe с цифрова апертура 1,25 е закрепен с два винта под предметната маса. Височината на позицията на кондензера е настроена фабрично и не се нуждае от регулиране от потребителя; кондензерът е центриран по отношение на оптичната ос. Застопоряването на позицията на кондензера елиминира риска от случайна промяна на правилната настройка. Предварително конфигурираният кондензер улеснява работата на студентите с микроскопа и освобождава повече време за научни занимания.<br />
Бутонът на кондензера регулира ирисовата диафрагма на апертурата. Цветната маркировка съответства на увеличението на обектива. За постигане на контрастно изображение с всеки обектив се препоръчва бутонът за регулиране на апертурата да се постави в позиция, която съответства на маркирания номер на обектива.</p>
<p><strong>Източник на светлина</strong></p>
<p>Илюминаторът за преминаваща светлина съдържа светодиод 3 W. Илюминаторът на светлина на микроскопа има функция за регулиране на цветната температура в диапазона от 3000 до 7000 K. Потребителят избира удобна за очите му цветна температура и я променя лесно с един бутон, когато например, изследването на даден обект изисква промяна на светлината.<br />
Животът на светодиода е 50 000 часа.</p>
<p><strong>Екран с течнокристален дисплей за състоянието</strong></p>
<p>На екрана с течнокристален дисплей върху основата на микроскопа се показват увеличението на обектива, яркостта и цветната температура на източника на светлина и режима на работа (“спящ”, “еко”).<br />
С помощта на екрана и два бутона ползващият микроскопа може да регулира яркостта, да избира цветната температура, да заключва регулирането на яркостта, да задава “спящия” режим и да настройва таймера за автоматично изключване.</p>
<p><strong>Ергономична конструкция</strong></p>
<p>Страните на “прозореца” в стойката оформят дръжки за пренасяне на микроскопа с две ръце. Конструкцията за скрито разполагане на захранващия адаптер и захранващия кабел подобрява естетиката на работното място и безопасността при пренасяне на микроскопа, както и опростява съхранението на уреда.</p>
<p><strong>Основни характеристики:</strong></p>
<ul>
<li>Наблюдение на прозрачни и полупрозрачни образци по метода на светлото поле с пропусната светлина</li>
<li>Тринокулярна глава с вертикална тръба за монтиране на цифрова камера и регулиране на височината за удобство на наблюдаващия; разделяне на лъчите 0/100 и 100/0</li>
<li>Кодирана револверна глава: яркостта на източника на светлина се задава автоматично в зависимост от избрания обектив</li>
<li>Предварително конфигурираният кондензер с цветно кодирано увеличение на обектива предоставя възможност за бързо и точно настройване на апертурата</li>
<li>Илюминатор за преминаваща светлина – енергоспестяващ светодиод 3 W със срок на експлоатация до 50 000 часа</li>
<li>Интелигентна система за управление на осветлението: автоматичен избор на яркост при смяна на обективите и регулиране на цветната температура, заключване на настройката на яркостта, таймер за автоматично изключване и екран с течнокристален дисплей за състоянието</li>
<li>Предметна маса без рейка за позициониране </li>
<li>Ергономична стойка с дръжки за пренасяне и скрито разполагане на захранващия кабел и захранващия адаптер</li>
<li>Компактната и лека конструкция улеснява съхранението на микроскопа върху високи рафтове</li>
</ul>
<p><strong>Комплектът включва:</strong></p>
<ul>
<li>Стойка със светлинен източник за преминаваща светлина, механизъм за фокусиране, предметна маса, монтировка за кондензер и револверна глава с обективи</li>
<li>Кондензер Abbe</li>
<li>Тринокулярна глава</li>
<li>Планахроматичен обектив с корекция до безкрайност: 4x/0,10</li>
<li>Планахроматичен обектив с корекция до безкрайност: 10x/0,25</li>
<li>Планахроматичен обектив с корекция до безкрайност: 40x/0,65 (пружинно натоварен)</li>
<li>Планахроматичен обектив с корекция до безкрайност: 100x/1,25 маслен (пружинно натоварен)</li>
<li>Окуляр 10x/20 mm с голямо разстоянието от очите (2 бр.)</li>
<li>Чашка за окуляр (2 бр.)</li>
<li>Адаптер за камера с С-образна монтировка</li>
<li>Светлинен филтър</li>
<li>Бутилка с имерсионно масло</li>
<li>Захранващ адаптер и захранващ кабел на микроскопа</li>
<li>Покривало против прах</li>
<li>Ръководство за потребителя и гаранционна карта</li>
</ul>
<p><strong>Предлагат се по заявка:</strong></p>
<ul>
<li>Цифрова камера</li>
<li>Калибрационен образец</li>
<li>Монитор</li>
</ul>
Виж повече
Допълнителна информация
Виж повече
Информация за производителя
| Контакт | [email protected] |
| Адрес | ул. Акад. Стефан Младенов 46, София, 1700, България |
| Уебсайт | https://magusmicro.bg/ |
Виж повече
Ние от PIC.bg постоянно полагаме усилия информацията на тази страница да е точна. В редки случаи съдържанието може да е некоректно. Всички снимки са с информативна цел и е възможно да съдържат аксесоари, които не са включени в стандартния пакет. Някои от спецификациите или цените могат да бъдат променяни от производителя без предизвестие или да съдържат експлоатационни грешки. Всички промоции, посочени в сайта, се предлагат до изчерпаване на количествата.
Отзиви
0.0
0 отзива.
5
0
4
0
3
0
2
0
1
0
Оцени продукта
Добави отзив